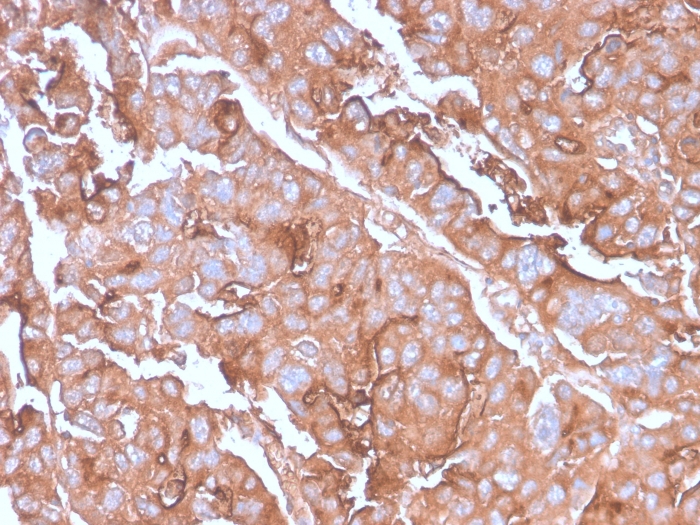

Formalin-fixed, paraffin-embedded human Colon Carcinoma stained with MUC1 Rabbit Recombinant Monoclonal Antibody (MUC1/2980R).

Western Blot Analysis of MCF-7 cell lysate using MUC1 Rabbit Recombinant Monoclonal Antibody (MUC1/2980R).
This MAb recognizes full-length MUC1 in a glycosylation-independent manner and can bind to the fully glycosylated protein.The dominant epitope of this MAb is APDTR in the VNTR region. It reacts with the core peptide of the MUC1 protein, which is a member of a family of mucin glycoproteins that are characterized by high carbohydrate content, O-linked oligosaccharides, high molecular weight (200kDa) and an amino acid composition rich in serine, threonine, proline and glycine. The core protein contains a domain of 20 amino-acid tandem repeats that functions as multiple epitopes for the MAb. Incomplete glycosylation of some tumor-associated mucins may lead to variable unmasking of the multiple peptide epitopes leading to the observed differences in staining intensity between normal and malignant tissues. This MAb reacts with both normal and malignant epithelia of various tissues including breast and colon.
There are no reviews yet.